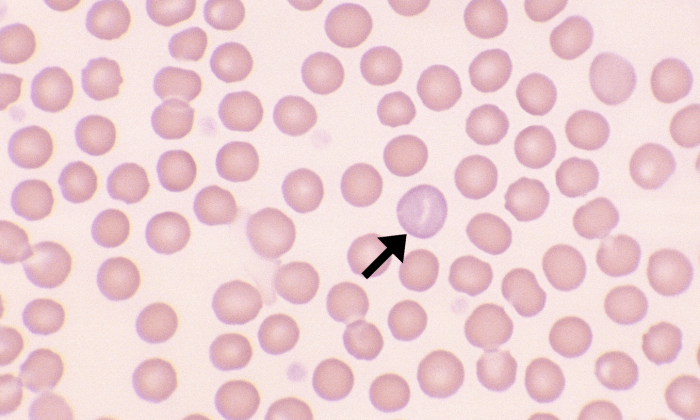
Normal Canine 4 (Polychromatophil) ARROWS

Normal Canine Erythrocytes
Morphology: relatively large, uniform red blood cells with central pallor.
Lifespan: 110 – 120 days
Other features: small numbers of polychromatophils, nucleated red blood cells, and Howell-Jolly bodies may be present in healthy non-anemic dogs. Puppies (4-8 weeks of age) may show microcytosis due to physiologic iron deficiency.



